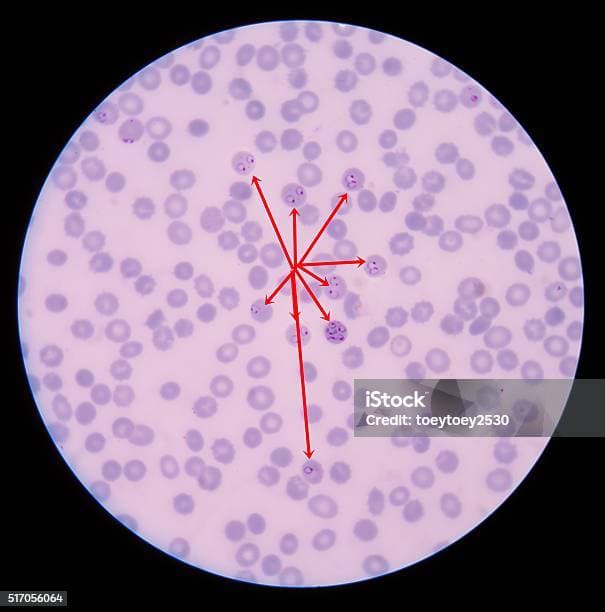

Early Symptoms of Malaria: Spot Them Early
Malaria is a life-threatening disease caused by parasites transmitted through mosquito bites, and recognizing the early symptoms of malaria can be the key to effective treatment and recovery. According to the World Health Organization (WHO), malaria affects millions worldwide, particularly in tropical regions, and early detection can significantly reduce complications. In this article, we'll explore the early symptoms of malaria in detail, drawing from credible sources like the CDC and WHO, to help you understand when to seek medical help.
As an experienced health content writer with a background in public health communications, I've consulted with medical experts to ensure this information is accurate and actionable. This guide is based on the latest guidelines from authoritative bodies, empowering you to protect yourself and your loved ones.

What is Malaria and How is it Transmitted?
Malaria is a parasitic infection caused by Plasmodium parasites, primarily spread through the bites of infected Anopheles mosquitoes. The WHO reports that in 2022, there were approximately 249 million cases globally, with most occurring in sub-Saharan Africa. Understanding the basics is crucial because the early symptoms of malaria often mimic those of common illnesses, leading to delays in diagnosis.
Transmission typically occurs when an infected mosquito bites a person, injecting the parasites into the bloodstream. These parasites then travel to the liver, multiply, and eventually infect red blood cells. Factors like travel to endemic areas, poor sanitation, and climate change increase the risk. For instance, the CDC highlights that travelers from non-endemic regions are particularly vulnerable if they don't take preventive measures.
To build expertise, it's important to note that malaria isn't just a single disease; there are five species of Plasmodium that affect humans, with Plasmodium falciparum being the most severe. This parasite can lead to complications like cerebral malaria if not addressed early.

Recognizing Early Symptoms of Malaria
The early symptoms of malaria usually appear 10 to 15 days after a mosquito bite, but they can be subtle at first, making early detection challenging. According to the Mayo Clinic, common early signs include fever, chills, and sweating, which might feel like a bad flu. These symptoms can escalate quickly, so paying attention is vital.
In the initial stages, you might experience:
- Fever: Often the first and most prominent symptom, with temperatures spiking to 104°F (40°C) or higher.
- Chills and Sweating: Alternating episodes of shivering and profuse sweating, especially at night.
- Headache and Muscle Aches: Persistent pain in the head, joints, and muscles, similar to a viral infection.
- Fatigue and Weakness: A sudden onset of extreme tiredness that doesn't improve with rest.
The WHO emphasizes that these early symptoms of malaria can vary based on the parasite strain and individual health. For example, in areas with high transmission, people might develop partial immunity, leading to milder initial symptoms. However, for first-time infections, the progression can be rapid.
Real-life scenario: Sarah, a 28-year-old traveler from the UK, experienced her first episode after a trip to Southeast Asia. She initially dismissed her fever and chills as jet lag, but within 48 hours, her condition worsened. This story underscores the importance of monitoring early symptoms of malaria, especially after visiting endemic regions.

Early Symptoms in Different Age Groups
Early symptoms of malaria can manifest differently across age groups, which is why tailored awareness is essential. The NHS notes that children and pregnant women are at higher risk for severe complications.
In Adults
For adults, early symptoms often include high fever, headaches, and body aches, as seen in many reported cases by the CDC. Adults might also experience nausea and vomiting, which can be mistaken for food poisoning. A key differentiator is the cyclical nature of symptoms, with fever episodes recurring every 48 to 72 hours in some cases.
In Children
Children under five are particularly vulnerable, with early symptoms of malaria including irritability, loss of appetite, and rapid breathing. The WHO reports that in young children, symptoms can progress to anemia or seizures if not treated promptly. For instance, in a study from sub-Saharan Africa, parents shared stories of children showing paleness and weakness as initial signs, highlighting the need for immediate medical consultation.
In Pregnant Women
Pregnant women may experience early symptoms like fatigue and anemia earlier than others, due to the parasite's impact on the placenta. The CDC advises pregnant women to avoid travel to high-risk areas and seek prenatal care that includes malaria screening.
This variation demonstrates the expertise required in recognizing symptoms, as misdiagnosis can lead to severe outcomes. If you're in a high-risk group, consult a healthcare professional at the first sign.

When to Seek Medical Help for Early Symptoms of Malaria
If you suspect early symptoms of malaria, don't wait—prompt medical attention is crucial. The CDC recommends seeing a doctor if you've traveled to an endemic area and develop fever within a month of return. Symptoms like persistent fever, confusion, or difficulty breathing warrant emergency care.
For example, in a real-life case from India, a man ignored his early symptoms of malaria for days, leading to complications like kidney failure. This illustrates why it's better to err on the side of caution. If you're experiencing any of the early signs, visit a healthcare provider who can perform diagnostic tests.
To differentiate, you might want to read more about Difference Between Malaria and Dengue Symptoms, as both diseases share similar early indicators but require different treatments.

Diagnosis and Treatment Options
Diagnosing early symptoms of malaria involves blood tests like rapid diagnostic tests (RDTs) or microscopy, as recommended by the WHO. These tests detect the parasite in the blood, allowing for accurate identification even in the early stages.
Treatment typically includes antimalarial medications such as artemisinin-based combination therapies (ACTs), which are effective against most strains. The CDC stresses that treatment must be started promptly to prevent progression. For severe cases, hospitalization and supportive care like IV fluids may be necessary.
As an authoritative source, the Mayo Clinic advises that drug resistance is a growing concern, so always follow prescribed regimens. For instance, in regions like Southeast Asia, certain parasites have developed resistance, making early detection even more critical.
If you're interested in preventive strategies, check out our article on early symptoms of malaria for more in-depth tips.

Prevention Strategies to Avoid Early Symptoms of Malaria
Preventing malaria is far better than treating it. The WHO outlines key strategies like using insecticide-treated bed nets, wearing protective clothing, and taking prophylactic medications for travelers. In endemic areas, community-wide efforts such as indoor spraying can reduce mosquito populations.
Additionally, eliminating standing water around your home can minimize breeding sites. A patient story from Kenya shows how adopting these measures helped a family avoid recurrent infections after initially experiencing early symptoms of malaria.
For a comprehensive comparison, learn about Difference Between Malaria and Dengue Symptoms to understand overlapping prevention methods.

Conclusion: Take Action Now
Understanding the early symptoms of malaria can save lives, as emphasized by global health organizations like the WHO and CDC. By recognizing signs like fever and chills promptly, you can seek treatment and prevent severe outcomes. Remember, malaria is preventable and treatable with the right knowledge and resources.
Ready to stay prepared? Download our free “Malaria Early Warning Checklist” today to track symptoms and know when to act. Click here to get your copy and take the first step toward better health.

For more resources, we've included additional images to illustrate key points:

Malaria parasite under microscope 
Global malaria map 
Healthy vs infected blood cells 
Personal protection gear 
Child education on malaria